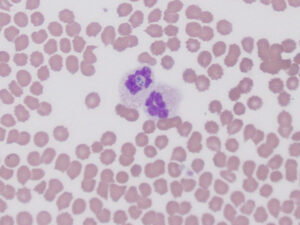
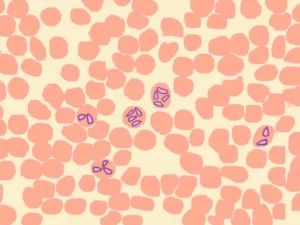

Što vlasnik kućnih ljubimaca treba znati?
Certificirani veterinarski pregledi
Specijalističke veterinarske ambulante Marković ovlaštene su od strane Hrvatskog kinološkog saveza za izdavanje certifikata o zdravstvenom stanju pasa i to za oftalmološki, kardiološki i test za gluhoću.